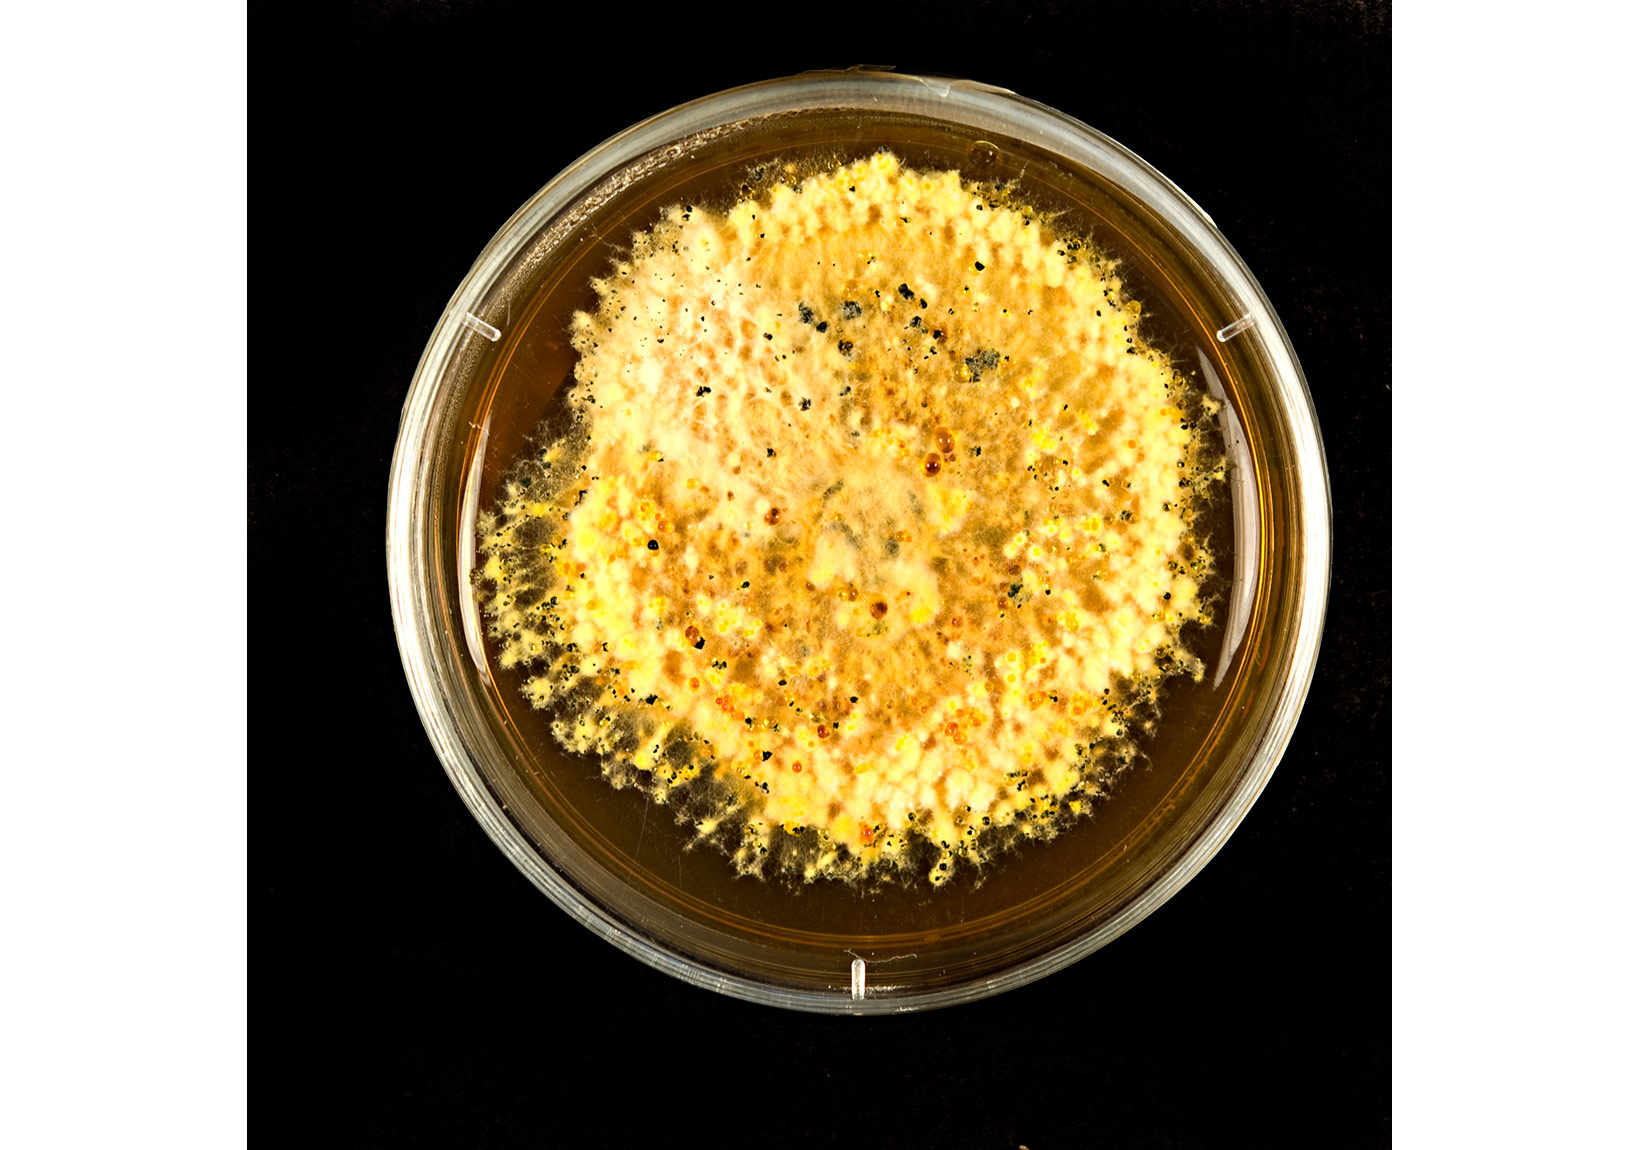

2015 yılı, Türkiye sanat dünyası için oldukça hareketli geçti. Hem birçok yeni sanatçı keşfettik hem de zaten bildiğimiz sanatçıları farklı projeleriyle tekrar izledik. Durum böyle olunca bu senenin en güçlü sanatçılarını tekrar hatırlamak amacıyla sanat yazarlarımıza 2015 yılında en dikkatlerini çeken üç ismi sorduk. Ve ortaya 25 kişilik bu liste çıktı.
Not: İsimler öncelik sırasına değil, alfabetik sıraya göre dizilmiştir.
Antonio Cosentino
Antonio Cosentino’nun resimlerinde günlük hayatın içinden, kişisel hafızasının derinliklerinden ya da yaşadığı şehrin görsel kültüründen sızarak gelen sayısız imge bulunuyor. Sanatçının son sergileri arasında, “Anne Ben Beton Dökmeye Gidiyorum” (Extramücadele ile, Studio-X, İstanbul, 2015), “Marmara’dan Kaçış: Stelyanos Hrisopulos Gemisi” (Salt Ulus, Ankara, 2015), “Marmara'dan Kaçanlar” (Bergsen & Bergsen, İstanbul, 2013) ve “Teneke Şehir” (Külah, İstanbul, 2013), Hafriyat Grubu'yla birlikte “Spare Time”, “Great Work” (Platform 3, Münih, 2011) ve “Tactics of Invisibility” (Thyssen-Bornemisza Art Contemporary, Viyana; Tanas, Berlin; ARTER, İstanbul, 2010-2011) yer alıyor. Cem Erciyes’in oyuyla listemize giren Cosentino’nun işleri de şu anda MAXXI Müzesi’nde gerçekleşen karma sergi "Istanbul: Passion, Joy, Fury"da sergileniyor.

Aslı Çavuşoğlu
Aslı Çavuşoğlu İstanbul’da yaşıyor ve çalışıyor. Projeleri kültürel ve tarihsel olguların bireylerce nasıl dönüştürüldüğünü, temsil edildiğini ve yorumlandığını inceliyor. Çeşitli mecralar üzerinden çalışan Çavuşoğlu, projelerinde sıkça bir tercüman, yazar ya da danışman rolü üstlenerek, ortak tarihlerimizin güvencesiz ve öznel doğasının altını çiziyor. "Taşlar Konuşuyor" isimli sergisiyle ARTER'de yer alan sanatçı, 14. İstanbul Bienali'nin de dikkat çeken isimlerindendi. Bu nedenle de Refik Akyüz’den oy alarak listemize girdi.

Aslı Narin
Görsel Sanatlar alanında İstanbul’da Sabancı Üniversitesi’nden lisans ve Londra’da Goldsmiths, University of London’dan yüksek lisans derecelerini alan Aslı Narin, Yıldız Teknik Üniversitesi’nde doktora tezini hazırlamaya devam ediyor ve Kadir Has Üniversitesi İletişim Fakültesi’nde öğretim üyeliği görevini sürdürüyor. Sanatçı Kasa Galeri’de gerçekleştirdiği "Dönüş" isimli sergisinden sonra, "Akış" isimli ikinci kişisel sergisiyle Öktem&Aykut Galeri'de yer aldı. Sanat yazarımız Seda Yörüker, Aslı Narin’in çalışmalarını takip etmemizi öneriyor.

Ayşe Gül Süter
1982’de İstanbul’da doğan Ayşe Gül Süter, New York’ta Tish School of the Arts’ta Animasyon ve Dijital Sanatlar Bölümü’nde öğrenim gördü. Yükselen genç bir sanatçı profili çizerek videolarını birçok galeride sergileme fırsatı yakaladı. Video, animasyon ve interaktif video yerleştirme türleri üzerinden projelerini kurgulamaya devam ediyor. Sanatçı 2013 yılında "Hareket" isimli sergisiyle PG Art Gallery'de yer almıştı. Seda Yörüker, Süter’in her ne kadar 2015 yılında kişisel sergi açmadıysa da bu yıl içinde katıldığı iki büyük sergi projesi "Dalgalar" ve "Plugin"de yer alan işlerinin New Media Art alanında öne çıkan, parlak bir sanatçı olduğunu bize gösterdiğini düşünüyor. Ve ekliyor: “Sanat ile bilim arasında üreten ve düşünen Ayşe Gül Süter gibi yeni isimler dikkate değer”.

Bahadır Baruter
Mimar Sinan Üniversitesi, Güzel Sanatlar Fakültesi, Resim Bölümü’nde eğitim alan sanatçı, profesyonel çizerliğe 27 yaşında başladı ve çeşitli mizah dergilerinde çizerlik yaptı. Baruter "Varlık Evhamı", "Senin Ailen Bir Yalan Yavrum" ve "Evim, Evim Güzel Evim" başlıklı kişisel sergileriyle x-ist'te sanatseverlerle buluştu. Baruter 24 Aralık itibariyle son kişisel sergisi "Mukadderat" ile x-ist'de olacak. Bu yılki Contemporary Istanbul’daki işleriyle dikkat çeken Batuer, Ebru Nalan Sülün’ün önerdiği isimler arasında yer alıyor.

Cansu Çakar
Cansu Çakar İzmir’de yaşayan ve çalışan bir sanatçı. 2006’da Dokuz Eylül Üniversitesi Güzel Sanatlar Fakültesi Geleneksel Türk Sanatları Bölümü’ne giren Çakar, sonrasında Budapeşte’deki Moholy-Nagy Sanat ve Tasarım Üniversitesi’nde grafik tasarım eğitimi aldı. Günümüzde Minyatür Atölye adındaki bağımsız atölyesinde çalışmalarına devam ediyor. Sanatçı, 14. İstanbul Bienali'ne 100° atölyesi ile dahil oldu ve Creative Çukurcuma'nın ilk sergisi olan karma serge "Komşu"da yer aldı. Cansu Çakar, yazarımız Saliha Yavuz’un bu yıl başarılı bulduğu isimlerden biri.

Ceylan Öztürk
1984 yılında Ankara’da doğdu. Anadolu Üniversitesi Güzel Sanatlar Fakültesi Heykel Bölümü’nde 2006 yılında lisansını, 2011 yılında da yüksek lisansını tamamladı. 2012 yılından beri Mimar Sinan Güzel Sanatlar Üniversitesinde Sanatta Yeterlik çalışmalarını sürdürüyor ve aynı bölümde öğretim elemanı olarak çalışıyor; çalışmalarını İstanbul’da devam ettiriyor. Sanatçı dördüncü kişisel sergisi “History in Lowercase” ile Şubat 2015’de ALAN İstanbul’da yer aldı. Ceylan Öztürk, Emre Zeytinoğlu’nun bu yıl önemsediği sanatçılar arasında.

Çınar Eslek
Çınar Eslek 2006 yılında Mimar Sinan Üniversitesi Güzel Sanatlar Fakültesi Resim Bölümü’nden mezun oldu. 2010’da Marmara Üniversitesi Resim Bölümü’nde bedensel acının bir deneyim olarak sanat yapıtına dönüşmesi üzerine yazdığı tezle yüksek lisansını tamamladı. Kişisel sergileri arasında “Keskinlikten Uzak”, “Bir de”, “Paralel Diyar”, “Farkında Değilim” yer alan sanatçı, son olarak geçtiğimiz ay Pg Art Gallery'de "Koyaanisqatsi" isimli sergisiyle sanatseverlerle buluştu. Mehmet Kahraman’a göre Çınar Eslek, 2015’in öne çıkan sanatçılarından biri.

Ege Kanar
Ege Kanar Sabancı Üniversitesi’nde Görsel Sanatlar ve İletişim Tasarımı Programı’nı tamamladıktan sonra Prag Performans Sanatları Akademisi’nde Fotoğraf alanında yüksek lisans yaptı. İşleri bellek ve mekan kavramlarının fotografik temsiline odaklanıyor. Sanatçı 2014'de "Bir Gün Herkes Heykeltıraş Olabilir" isimli sergide yer almıştı. Mehmet Kahraman’ın oyuyla listemizdeki yerini de aldı.

Erdal İnci
Erdal İnci 2005 yılında Hacettepe Resim Bölümü'nden mezun oldu. 2009’den bu yana yaşadığı İstanbul’da sokak sanatı, video ve dijial sanat gibi alanlarla ilgilendi. Son iki yıl içerisinde tekrar kavramı üzerine yaptığı videolarını GIF formatına dönüştürerek kişisel bloğunda yayınlamaya başladı. Uluslararası çeşitli karma sergilerin yanında, “Hareket Örünütleri” ismiyle ilk kişisel sergisini Bauart İstanbul’da gerçekleştirdi. Hareket, zaman ve titreşim gibi kavramlar üzerine araştırmaya, üretmeye ve online mecralarda paylaşmaya devam ediyor. Sanatçının “Berlin Wall : A Data Visualization” isimli video yerleştirmesi Contemporary İstanbul'da sergilendi. Sanatçı, Marcus Graf’ın dikkat çektiği isimlerden biri.

Erdoğan Zümrütoğlu
1970’te Konya’da doğan Erdoğan Zümrütoğlu, çalışmalarını İstanbul ve Berlin’de sürdürüyor. Sanatçı "Antonin Artaud Anısına", "Bir Şair, Bir Ressam", "Ben İçin Balballar", "Diklenme", "Yeryüzü Ayetleri" ve "Ya da" gibi kişisel sergilerde bulundu. Son olarak "Mürekkebi Koyu" isimli sergisiyle The Empire Project'deydi. Erdoğan Zümrütoğlu, Marcus Graf’ın önerdiği 2015’in öne çıkan sanatçılarından.

Hera Büyüktaşçıyan
Marmara Üniversitesi Güzel Sanatlar Fakültesi Resim Bölümü’nden mezun olan Hera Büyüktaşçıyan, işlerinde kimlik, hafıza, zaman ve mekan ile hayali bir bağ kurmak amacıyla “öteki” olma durumunu yokluk ve görünmezlik kavramlarıyla bir araya getirerek vurguluyor. Sanatçı yerel mitlerden, tarihi ve ikonografik unsurlardan yararlanarak, “öteki” için yeni bir anlatı olanağı oluşturuyor. Büyüktaşçıyan’ın işleri, şu anda MAXXI Müzesi’nde gerçekleşen karma sergi "Istanbul: Passion, Joy, Fury"da sergileniyor. Cem Erciyes ve Seda Yörüker, Hera Büyüktaşçıyan’ı bu yılın dikkat çeken sanatçılarından biri olarak önerdiler.
Gizem Akkoyunoğlu
Gizem Akkoyunoğlu’nun ilk kişisel sergisi "Ve Yolun Her Adımı" Sanatorium’da açıldı. Akkoyunoğlu daha sonra Orhan Yıldız ile birlikte "Gölgenin Hikayesi" isimli sergide yer aldı. 2011‘de Dokuz Eylül Üniversitesi Güzel Sanatlar Fakültesi Resim Anasanat Dalı’ndan mezun olan Gizem Akkoyunoğlu, aynı üniversite ve bölümde yüksek lisans eğitimini sürdürüyor. Sanatçı aynı zamanda İzmir’in önemli bağımsız kültür ve sanat girişimi Input/Output kurucularından. Ve listemize Saliha Yavuz’un önerisiyle girdi.

Kadir Akyol
Mardin Doğumlu Kadir Akyol, Mersin Üniversitesi Güzel Sanattlar Fakültesi Resim Bölümü'nde okudu. Ankara Gazi Üniversitesi Güzel Sanatlar Fakültesi Resim Ana Sanat Dalı'nda yüksek lisans eğitimini tamamladı. Sanatçı "Bir Fenomen Olarak İmge" isimli sergisiyle Galeri ARK'ta yer almıştı. Ebru Nalan Sülün’e göre 2015’in dikkate alınması gereken 25 sanatçısından biri olarak öne çıkıyor.

Mehmet Ali Boran
Sanatçı Mehmet Ali Boran evrensel değerler ile yerel deneyimlerin diyalogları haline getirdiği yapıtları ile bireyin ve toplumsal değerlerin sürgün olma durumuna, yeteneğin ve birikimin göçebelik hallerine, toplumsal inşaların, yıkım ve yeniden yapım süreçlerini yorumluyor. Heykel, yerleştirme ve video sanatının dilini kullanan sanatçının "Hadi Bir Daha Deneyelim" başlıklı kişisel sergisi geçtiğimiz ay Videoist Mardin'de gösterildi. Boran, Emre Zeytinoğlu’nun dikkatini çeken sanatçılardan biri.

Mehtap Baydu
Mehtap Baydu 2000 yılında Hacettepe Üniversitesi Güzel Sanatlar Fakültesi Heykel Bölümü’nden mezun oldu. 2001-2002’de Prof. Dr. Rahmi Aksungur’un Ankara Devlet Mezarlığı ‘’Cumhuriyet Tarihi Anıtsal Heykel Düzenlemesi’’nde asistanlık yaptı. 2002-2005 yılları arasında çalışmalarına Türkiye’nin yanı sıra Almanya’da devam etti. 2010’da Kassel Üniversitesi’ndeki (Kunsthochshule Kassel) yüksek lisans eğitimini tamamladı ve Frankfurt’a yerleşti. Sanatçı "Koza" isimli son sergisiyle Galeri Nev'de yer aldı. Nazlı Pektaş, Mardin Bienali’nde tanıdığı sanatçının figüratif kağıt heykelleriyle ilgisini çektiğini belirterek Mehtap Baydu’ya dikkat çekiyor.

Özge Topçu
1987 Kırklareli doğumlu Özge Topçu’nun sanatsal çalışmaları modernist ulus kimliği yapılandırılması ve mimari konularında yoğunlaşıyor. La Turquie Construit adlı çalışması 2014 yılında Mamut Art Projesi kapsamında seçilen sanatçı, 2014 yılında Rotary Sanat Ödülü yarışmasında ikincilik ödülü kazandı. Siemens “Sınırlar Yörüngeler” 15-16 yarışması ile “Türkiye´ den Yeni Nesil Çağdaş Sanatçılar” yarışmalarında finalist olarak bulundu. Sanatçı 2015 yılında Kuad Gallery’de “İnce Ayarlı ve Çoğul” isimli karma sergide yer aldı. Emre Zeytinoğlu’nun listemize kattığı genç sanatçıyı, ilerleyen yıllarda çokça takip edeceğiz gibi duruyor.

Özlem Günyol & Mustafa Kunt
2001 yılında Hacettepe Üniversitesi Heykel Bölümü’ndeki eğitimlerini tamamlayan Günyol & Kunt, sonrasında Frankfurt Sanat Okulu’na devam ettiler ve bu okulu meister (usta) olarak bitirdiler. 2005’ten bu yana iş birliği yapan Günyol & Kunt bugüne kadar 10’un üzerinde kişisel sergi açtılar ve uluslararası birçok karma sergide yer aldılar. İkilinin son sergisi "an-be-an" Aralık 2015’de Dirimart'da gösterildi. Nazlı Pektaş, “Özlem Günyol & Mustafa Kunt ikilisi çalışmalarıyla bu yıl ilgimi çeken sanatçıların başında geliyor” diyor.

Recep Serbest
Marmara Üniversitesi Güzel Sanatlar Fakültesi'nde Resim Bölümü'nde eğitim alan Recep Serbest çalışmalarına ve yaşamında İstanbul'da devam ediyor. 2015 yılında Mamut Art Project'e katılan sanatçı, fuarda yağlıboya çalışmalarıyla yer almıştı. Marcus Graf, Recep Serbest’i 2015’in öne çıkan sanatçılarından biri olarak değerlendiriyor.

Sarkis
Günümüzün önde gelen kavramsal sanatçılarından Sarkis, İstanbul Güzel Sanatlar Akademisi’nde (Mimar Sinan Güzel Sanatlar Üniversitesi) öğrenim gördü. İlk sergisini 1960 yılında İstanbul Sanat Galerisi’nde açan sanatçı, çalışmalarını 1964 yılında gittiği ve atölyesinin de bulunduğu Paris’te sürdürüyor. Sanatçı bu yıl en çok 56. Venedik Bienali’ndeki Türkiye Pavyonu’nda yer alan Defne Ayas küratörlüğündeki Respiro başlıklı yerleştirmesiyle konuşuldu. Sarkis, Cem Erciyes’in listemiz için önemle vurguladığı sanatçılardan.

Selin Balcı
Selin Balcı, West Virginia Üniversitesi'nin Güzel Sanatlar Bölümü'nden mezun olduktan sonra, 2012 yılında Maryland Üniversitesi'nde stüdyo sanatları alanında yüksek lisans eğitimini tamamladı. 2008´den beri Amerika´nın Maryland eyaletinde sanat çalışmalarını sürdürüyor ve iki ayrı üniversitede sanat tarihi ve dizayn dersleri veriyor. Balcı çalışmalarında bilim ve sanatı harmanlayarak steril laboratuvar ortamında görmeye alışık olduğumuz mikroorganizmaları Petri kabı ortamından ayırarak kanvas üzerinde kullanıyor. Sanatçı son olarak "40 Metre // 4 Duvar // 8 Küp" isimli grup sergisinde yer aldı. Selin Balcı’yı 2015’in öne çıkan sanatçıları arasında öneren Nazlı Pektaş, “Balcı, çalışmalarında hem sosyal ikilemlere ve varoluşumuzun temel prensiplerine gönderme yapmakta hem de sosyal çatışmalara dikkat çekmektedir” diyor.
Sinem Dişli
Sinem Dişli, 1982 yılında Urfa'da doğdu. 2004’te Dokuz Eylül Üniversitesi Güzel Sanatlar Bölümü'nü, 2007’de Marmara Üniversitesi Fotoğrafçılık Bölümü'nde yüksek lisans eğitimini bitirdi. Bu arada asistan küratör olarak İstanbul Modern Sanat Müzesi'nin Fotoğraf Bölümü'nde çalıştı. Son döneminde İstanbul ve New York arasında çalışan sanatçı, geçtiğimiz aylarda The Empire Project'de "Cereyan" isimli sergisiyle gerçekleştirdi. Fotoğraf, enstelasyon ve videoların yer aldığı sergisinde, doğup büyüdüğü şehir olan Urfa’dan başlayarak Mezopotamya’ya odaklanıyordu. Sinem Dişli, Refik Akyüz ve Saliha Yavuz’un bu yıl takip edilmesini önerdiği isimlerden.
Tayfun Gülnar
Sanatçı zihninden, özel yaşantısından ve insanlık tarihinden özneleri, objeleri ve mekanları sezgisel bir yolla bir araya getirdiği kompozisyonlarında, gerçeklikle hayal dünyası arasında gidip gelen ortamlar tasarlıyor. Bu ortamlar onun soyutlamacı dili tercih etmesinin doğal bir sonucu. Sıklıkla sıcak-soğuk, sağlam- tekinsiz, öfke-huzur gibi kutupların gerilimlerinden faydalanırken resim geleneğinin sağlam temellerine oturttuğu başarılı boyama tekniğini gözler önüne seriyor. Gülnar 2014 yılında "İmgelere Övgü" isimli sergisiyle Derinlikler Sanat Merkezi'nde yer almıştı. Ve Mehmet Kahraman’ın öne çıkanlar arasında önemsediği bir isim kendisi.

Tuba Yalçınkaya
Tuba Yalçınkaya’nın ilk kişisel sergisi "Tüm Güzel Rüyalara", kadının doğurganlık işlevi üzerinden yüceltilirken, cinsel arzuları nedeniyle aşağılandığı, dışlandığı, şiddete maruz kaldığı ataerkil sistemde, sanatçının bu yapıya direnen bilinçaltına bir yolculuk niteliğindeydi. Sanat üretiminde ve özellikle desenlerinde mekan üzerine düşüncelerini merkeze alan sanatçı son olarak Öktem&Aykut’ta "Dağın Belleği" isimli solo sergisiyle yer aldı. Refik Akyüz, Tuba Yalçınkaya’yı 2015’in başarılı sanatçılarından biri olarak değerlendiriyor.

Yonca Karakaş
1982, Diyarbakır doğumlu sanatçı Yıldız Teknik Üniversitesi, Sanat Tasarım Fakültesi’nde Fotoğraf ve Video Bölümü’nde eğitimini tamamladı. Sanatçı çalışmalarında genel olarak gerçeklik olarak gördüğümüz her şeyin ‘şeyler’ arasında kurduğumuz zamansal ve uzamsal ilişkiler olduğunu yansıtmaya çalışıyor. Tüm serilerinde genel olarak iyi olanın tümüyle tekin olmadığını, pastel tonların içersinde kurguladığı şüpheli durumlarla bir şekilde güzel başlayan bir rüyanın kabusa dönüştüğü o anı hissettirmeye çalışıyor. Bu yıl "Weltschmerz" isimli karma sergiyle Pg Art Gallery'de yer alan sanatçı, Ebru Nalan Sülün’ün oyuyla listemizde yerini alıyor.

Jüri üyelerimiz:
Radikal Yayın Yönetmeni Cem Erciyes
Öğr.Gör. Sanat Tarihçi, Sanat Eleştirmeni (AICA/Yönetim Kurulu Üyesi) Ebru Nalan Sülün
Sanatçı, teorisyen ve akademisyen Emre Zeytinoğlu
Doç. Dr. Sanat Tarihçi, yazar, küratör Marcus Graf
REM Art Space kurucusu, küratör Mehmet Kahraman
Öğr.Gör. Sanat tarihçi ve Sanat Yazarı Nazlı Pektaş
Kültür Yöneticisi Refik Akyüz
Bağımsız sanat yöneticisi Saliha Yavuz
Editör, Sanat Yazarı, Sanat Tarihçi Seda Yörüker